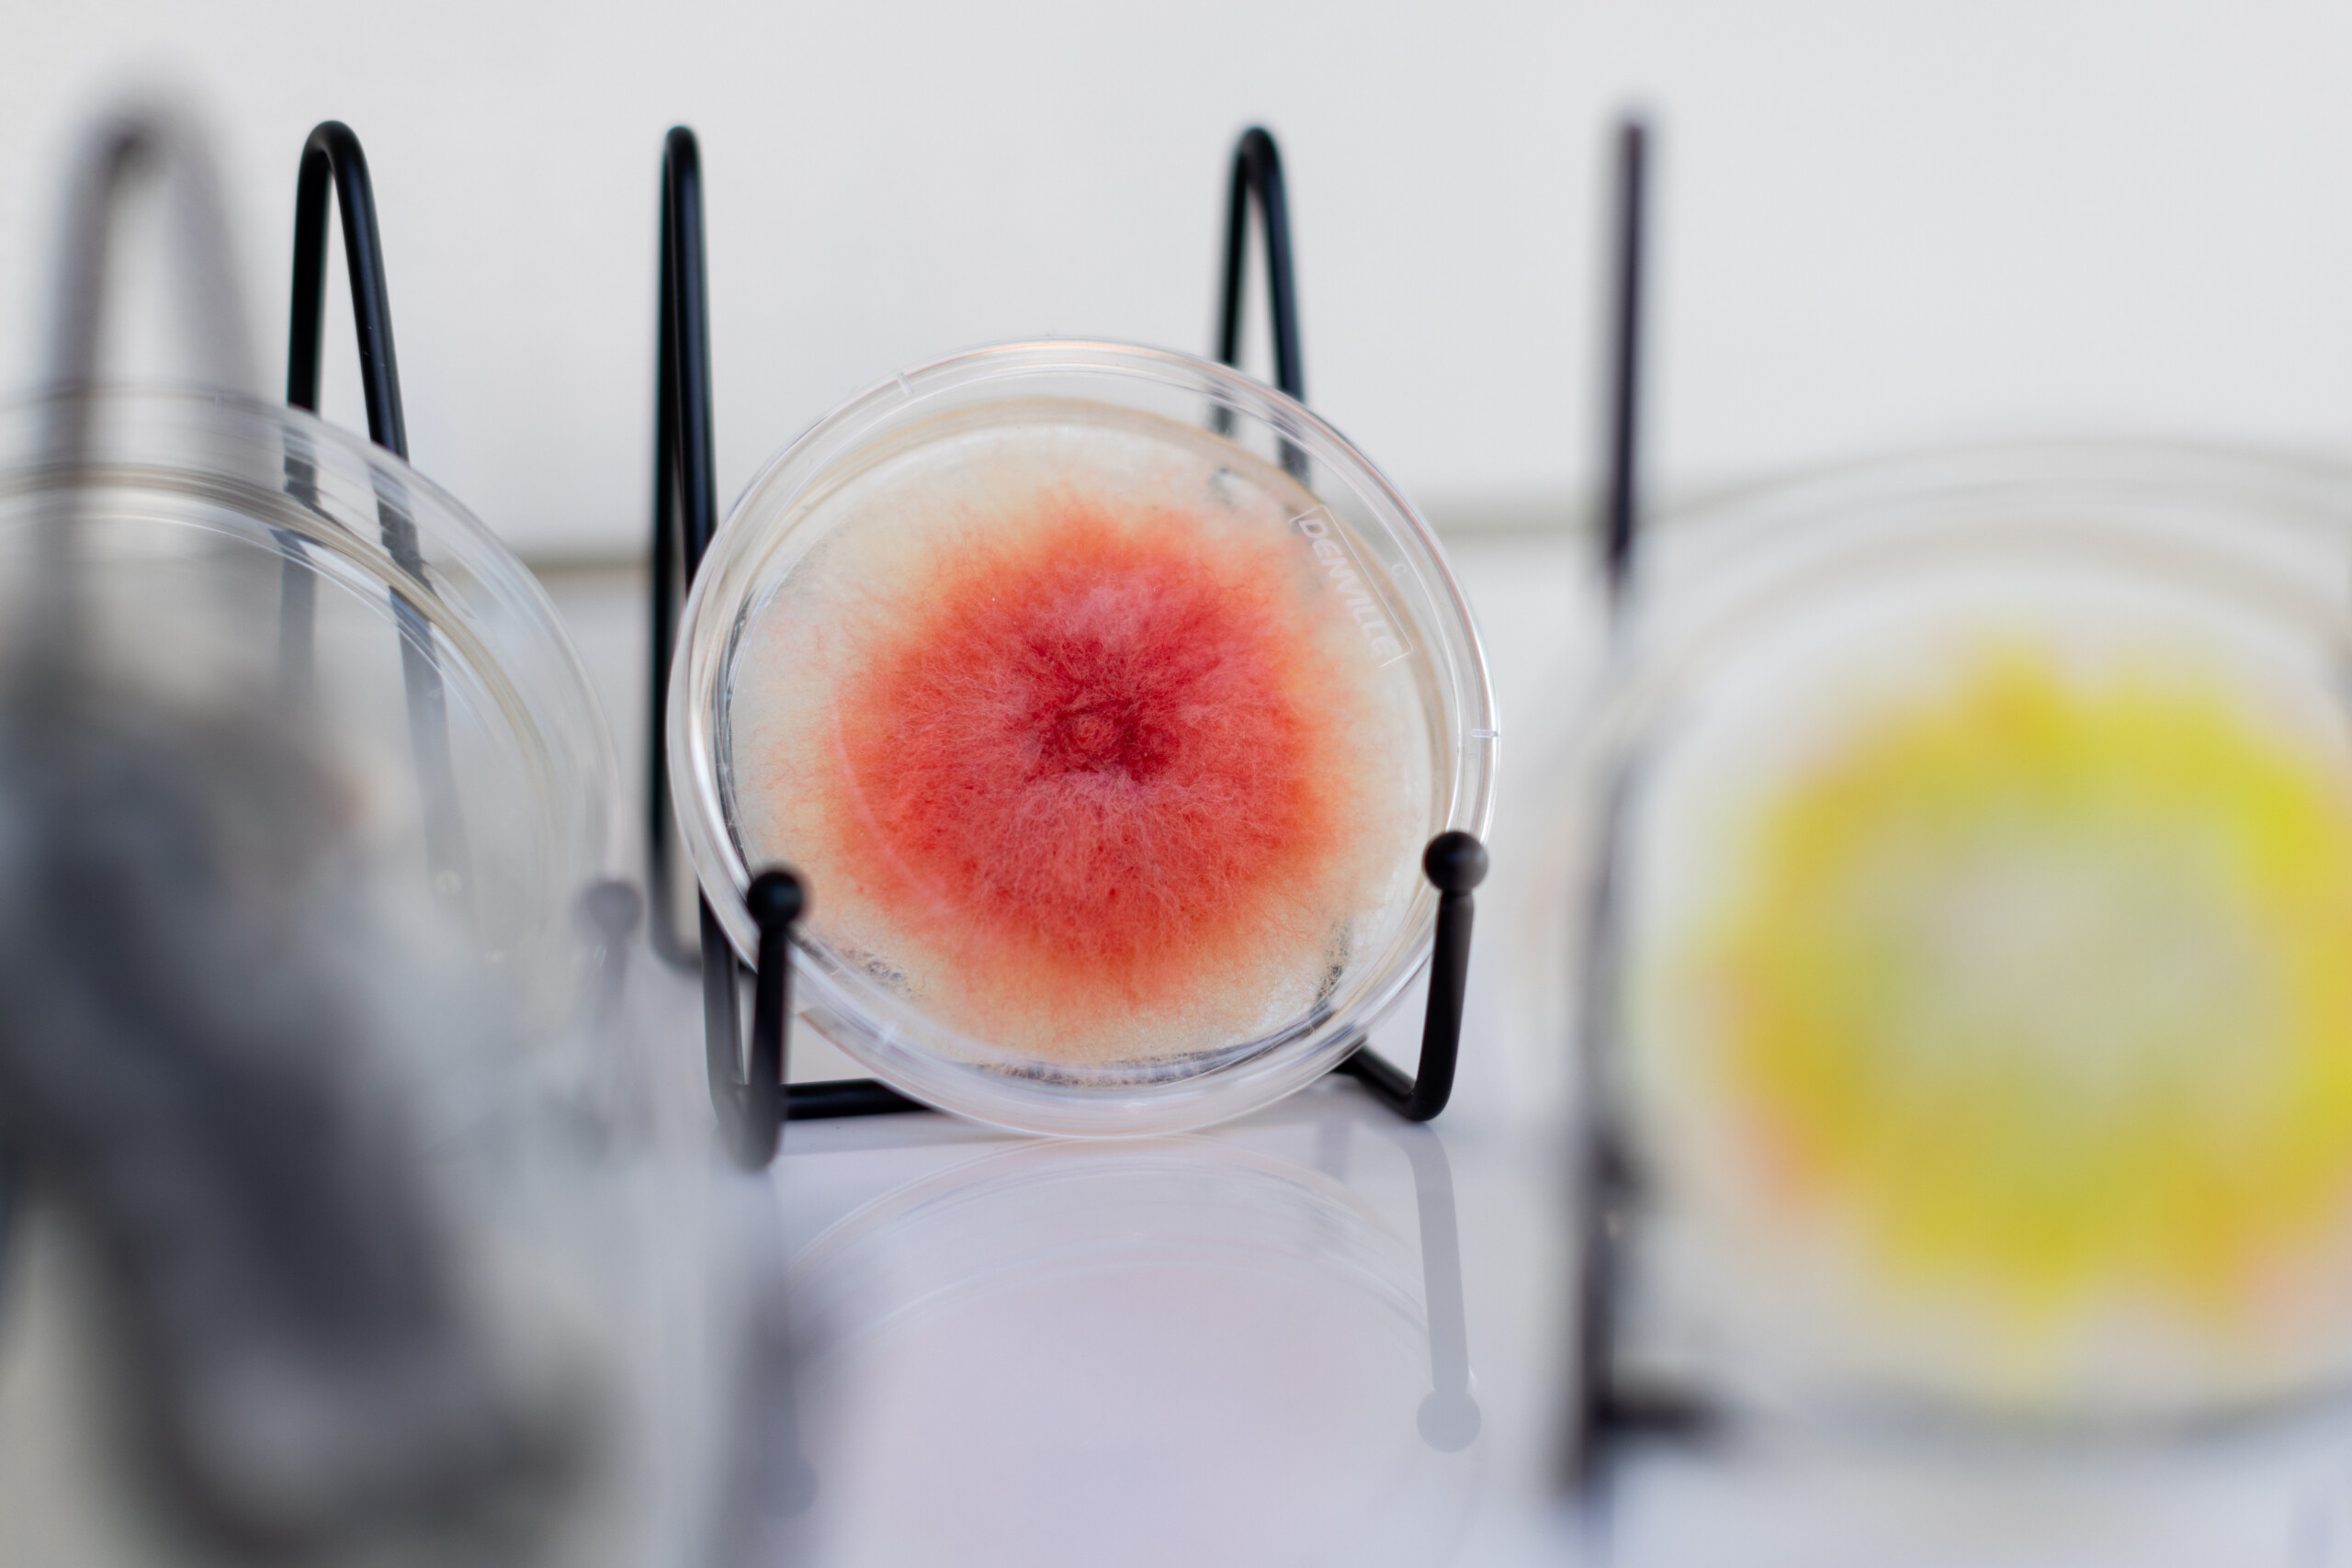

John D. Wiley Gallery for Art in Science
Now open! Stop by the northwest corner of the Discovery Building to explore the gallery during regular building open hours.
Thank you to all the wonderful donors who have made this gallery, a reality. To give a contribution to the continued growth of this dynamic new space, please click here.
The John D. Wiley Gallery for Art in Science is a unique space where art meets science, sparking curiosity and wonder in every visitor.
Housed in the Wisconsin Institute for Discovery, this gallery is embedded in a building filled with cutting-edge research, and provides a new perspective and medium for the community to learn about and enjoy scientific exploration.
Here, visitors can explore the intersection of artistic creativity and scientific discovery through carefully curated wonders inspired by the ground-breaking research happening above and below. This collection celebrates the beauty of natural patterns, the elegance of mathematical forms, the mystery of the cosmos, and more as it relates to the past, present, and future of WID.
We hope to invite you to immerse yourself in these installations that illustrate the forces of nature and the power of science.
In addition to the works housed in the Wiley Gallery space, we invite visitors to explore more 2D art around the corner in Hub Central, including Science to Street Art murals and works from WID researchers!
This gallery would not have been possible without our gracious donors and we thank them again for helping bring this vision to life. We are still accepting gifts to support the longevity of the gallery and continue to provide this free and accessible space for all to enjoy the intersection of the arts and sciences. Gifts can be given directly here (https://supportuw.org/giveto/wileygallery) or if you would prefer to speak directly with a member of the gallery team, we are always open to hearing your ideas and suggestions and can be reached at gallery@wid.wisc.edu.
Our thanks to SV Heart Photography for capturing the vibrancy of the gallery with these wonderful photos!